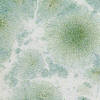
9540 Morgentau

Cookie-Einstellungen
Diese Website benutzt Cookies, die für den technischen Betrieb der Website erforderlich sind und stets gesetzt werden. Andere Cookies, die den Komfort bei Benutzung dieser Website erhöhen, der Direktwerbung dienen oder die Interaktion mit anderen Websites und sozialen Netzwerken vereinfachen sollen, werden nur mit Ihrer Zustimmung gesetzt.
Konfiguration
Technisch erforderlich
Diese Cookies sind für die Grundfunktionen des Shops notwendig.
"Alle Cookies ablehnen" Cookie
"Alle Cookies annehmen" Cookie
Ausgewählter Shop
CSRF-Token
Cookie-Einstellungen
Individuelle Preise
Kunden-Wiedererkennung
Kundenspezifisches Caching
Session
Währungswechsel
Komfortfunktionen
Diese Cookies werden genutzt um das Einkaufserlebnis noch ansprechender zu gestalten, beispielsweise für die Wiedererkennung des Besuchers.
Merkzettel
Statistik & Tracking
Endgeräteerkennung
Partnerprogramm
7,90 € *
Inhalt:
200 Milliliter
(3,95 € *
/ 100 Milliliter)
inkl. MwSt. zzgl. Versandkosten
Lieferzeit ca. 5 Tage
- Artikel-Nr.: BO9540
Intensive grüne fächerförmige Specks auf champagnerfarbenem Untergrund. mehr
Produktinformationen "9540 Morgentau"
Intensive grüne fächerförmige Specks auf champagnerfarbenem Untergrund.
Weiterführende Links zu "9540 Morgentau"
Bewertungen lesen, schreiben und diskutieren... mehr
Kundenbewertungen für "9540 Morgentau"
Bewertung schreiben
Bewertungen werden nach Überprüfung freigeschaltet.
Zuletzt angesehen
